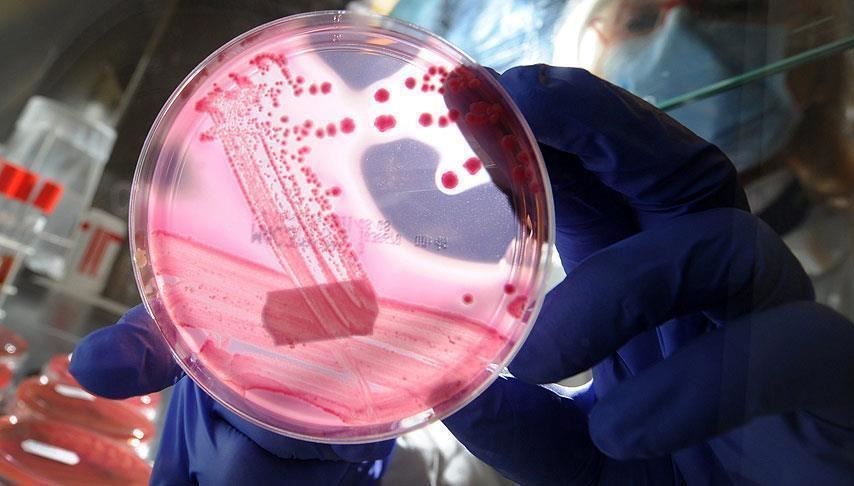
Prostat kanserinde yeni teşhis: Tükürükle tespit ediliyor

İngiltere’de, uzmanlar prostat kanserinin tespiti için tükürük testi geliştirdi.
Erkek DNA’sındaki genetik varyantları tahlil eden testin, prostat kanseri riskini kıymetlendirmek için mevcut yoldan daha düzgün performans gösterdiği görüldü.
130 GENETİK VARYANT DEĞERLENDİRİLİYOR
Yeni geliştirilen testte prostat kanseri riskinin artmasıyla bağlantılı olduğu bilinen 130 genetik varyantı kıymetlendirmek için tükürük inceleniyor. Bu sayede kişinin hastalık açısından yüksek risk altında olup olmadığı belirleniyor.
6 bin 300 erkekte denenen yeni yol sayesinde şimdiden iki kardeşin hayatı kurtuldu.
TÜKÜRÜK TESTİ HAYATLARINI KURTARDI
Dheeresh Turnbull, klâsik test yaptırdığında hastalık riskinin düşük olduğuna dair sonuç aldığını lakin yeni tükürük testini yaptırdığında ömrünü tehdit eden bir tümör olduğunu öğrendiğini söyledi.
Kardeşi Joel Turnbull da tükürük testi sonrası agresif bir prostat tümörüne sahip olduğunu öğrendi.
Uzmanlar bu çalışmayla kanser olduğu tespit edilenlerin, sırf klâsik yollarla kıymetlendirilmesi halinde yüzde 74’ünde kanserin tespit edilemeyeceğini söylüyor.
BU ARAŞTIRMAYLA GİDİŞAT DEĞİŞTİRİLEBİLİR
New England Journal of Medicine mecmuasında yayınlanan araştırma prostast kanserinde gidişatı değiştirebilir yorumları yapılıyor.
Şu anda prostat kanseri ya da prostat büyümesi üzere rahatsızlıkları denetim etmek için spesifik antijen PSA kan testi uygulanıyor.
Ulusal Sıhhat Servisi rutin testler yapmıyor. lakin Mahalle hekimlikleri prostat kanseri olduğundan şüphelendiği şahıslara PSA testi öneriyor.
Uzmanların yeni bulduğu sistem erken teşhis umutlarını artırdı. Yeni tükürük testi, yanlış müspet sonuç sayısını azalttığı üzere, PSA testinden daha yüksek oranda agresif kanser tespit edebildiği için bir ek tarama aracı olarak kullanılabilecek.